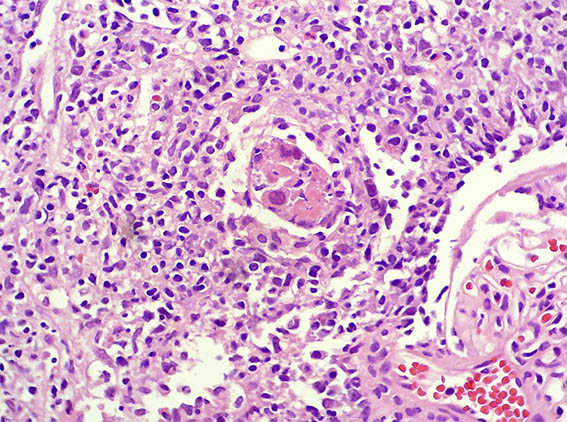
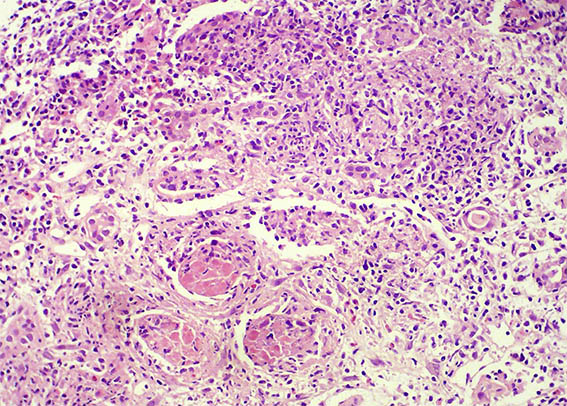

|
|
CASE
112 (June 2015)
Clinical information
The patient is a 32-year-old man, kidney transplanted 18 months ago due to end-stage renal disease of unknown cause. A cellular rejection episode was evidenced in the first year. Good kidney function in the last control (16 post-transplantation months). Now in a new control the serum creatinine has risen to 1.9 mg/dL. Mild proteinuria and microscopic hematuria, no other abnormalities.
See the images of the renal allograft biopsy.

Figure 1. H&E, X100.

Figure 2. H&E, X200.
Figure 3. H&E, X400.

Figure 4. H&E, X400.

Figure 5. H&E, X400.
Figure 6. H&E, X200.

Figure 7. Methenamine-silver, X200.

Figure 8. Masson´s trichrome, X200.
What is your diagnosis?
See
diagnosis and discussion
[Top]
|
|